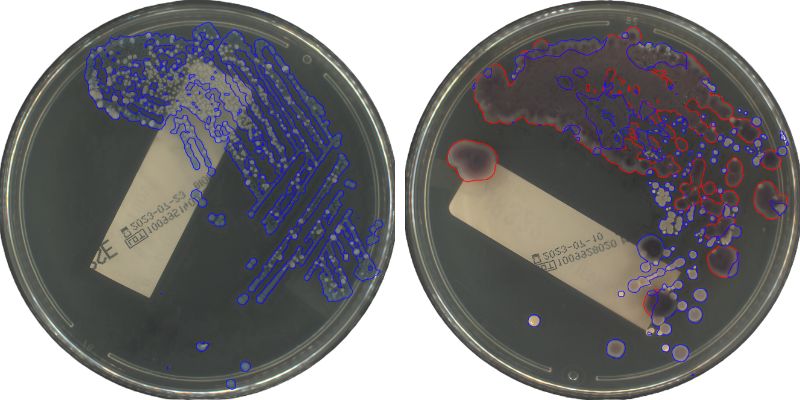

- Diagnostics
Categories:
In recent articles, we have been reflecting on the challenges faced by clinical microbiology laboratories. We have highlighted the growing importance of digitalization in this field, as well as the imperative need to provide these laboratories with new tools that improve their operability and accelerate diagnostic processes. In addition, we have underlined the importance of having compact and modular solutions that allow scalability according to future needs.
In this context and presented at ECCMID 2024, Sener stands out once again by presenting Ai5 Lab, a revolutionary solution in the automation of clinical microbiology laboratories.
Ai5 Lab emerges in a market where innovation and efficiency are key.
- Excellent streaking quality
- Dual growth/time protocols
- Continuous plate reading – Alarm generation
- Digital Microbiology – Open AI Platform
- Productivity, efficiency, and reliability
- Modular & scalable solution
Modular automation vs. massive, inflexible solutions
Ai5 Lab, as opposed to conventional solutions characterized by its large size and rigidity, redefines the landscape of automation in clinical laboratories. Ai5 Lab, being more compact, modular and scalable, breaks with tradition by offering a more flexible and adaptive alternative.
This modularity not only provides flexibility in laboratory configuration, but also allows for more precise adaptation to the specific needs of each facility.
In addition, Ai5 Lab stands out as the system that requires the least space in the laboratory and the only one that can be installed without the need for free space around its perimeter, thus optimizing the use of space and providing greater efficiency in environments with space limitations.
AUTOPLAK: High-quality and flexible streaking
The Autoplak streaking system, currently used by many laboratories worldwide, offers significant advantages for clinical microbiology laboratories. Its precise and uniform distribution of samples on agar plates reduces human error and ensures consistent results. It automates the streaking process, increasing processing capacity and reducing waiting times.
In addition, it saves time by eliminating repetitive manual tasks, allowing more focus on analysis and diagnostics. It is flexible, compatible with various sample types and plate sizes. It reduces waste by minimizing manual handling, promoting sustainable practices.
In short, Autoplak improves efficiency, accuracy and sustainability in the laboratory while maintaining high quality seeding and isolation.
AIPLAK: Smart Incubation: Dual Growth/Time Protocol – Continuous Monitoring
Ai5 Lab’s smart incubation system stands out in the market for its exclusivity: it has two complementary imaging systems.
On the one hand, it offers a continuous monitoring system that allows the growth of samples to be followed uninterruptedly, generating alarms when detecting any sign of growth in those plates designated as critical. On the other hand, it incorporates a second system that captures detailed images of the samples, digitizes them, and uses artificial intelligence algorithms to analyze and determine the specific characteristics of that growth.
This advanced platform combines management protocols based on both time and sample growth, providing the laboratory with a unique tool to deal with emergency situations, efficiently optimize workflow processes, and thus contribute to more effective operation and accelerated results in the laboratory.


“This new continuous monitoring technology with dual protocol could be a game-changer in the clinical laboratory sector, as it is very easy to operate and a really valuable tool to consider in the daily workflow.”
Not only does it automate workflow processes, but it also accelerates detection through continuous reading, setting a new standard in laboratory efficiency and providing innovative tools for laboratory management.
AI Modules: From Digitization to Customizable AI Algorithms
However, what really stands out in Ai5 Lab is its adaptable library of artificial intelligence (AI) algorithms. This innovation represents a milestone in sample analysis, improving both the accuracy and speed of diagnosis. Built-in AI algorithms not only interpret the results, but also evolve over time, constantly optimizing your ability to advise.
It is important to note that this library encompasses two types of algorithms: continuous monitoring and zenithal image algorithms, both of which complement each other.
Ai5 Lab goes above and beyond by offering an end-to-end solution, from the digitization of samples to the implementation of these customizable algorithms, providing a complete and advanced approach to microbiological analysis.
“The technology and algorithms are exceptionally easy to operate and represent valuable tools to consider in the microbiologist’s daily workflow. Its accuracy suggests potential for process optimization and improved efficiency in laboratory procedures.”
Thanks to its digitization software, Ai5Lab allows the evaluation and definition of the following tasks on each plate to be carried out in an efficient and user-friendly way. This is achieved by complementing the images with other types of information received from the LIS, without the need to manipulate the plates, and by dumping the results directly into the LIS.
In summary, Sener’ Ai5 Lab represents a significant advance in the automation of clinical microbiology laboratories. With its modular approach, dual imaging systems, and a library of customizable AI algorithms, this solution not only optimizes existing processes, but also sets a new standard in the efficiency and accuracy of microbiological diagnostics.
In a world where speed and accuracy are crucial in healthcare, Ai5 Lab is positioned as an indispensable tool for clinical laboratories in their quest to offer faster, more accurate and more reliable diagnoses.ara laboratorios clínicos en su búsqueda por ofrecer diagnósticos más rápidos, precisos y confiables.






